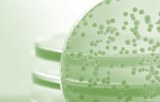
Media

Phytopathology products
Plant pathology (also phytopathology) is the study of diseases in plants caused by pathogens (infectious organisms) and environmental conditions (physiological factors). Organisms that cause infectious disease include fungi, oomycetes, bacteria, viruses, viroids, virus-like organisms, phytoplasmas, protozoa, nematodes and parasitic plants. Not included are ectoparasites like insects, mites, vertebrate, or other pests that affect plant health by eating of plant tissues. Plant pathology also involves the study of pathogen identification, disease etiology, disease cycles, economic impact, plant disease epidemiology, plant disease resistance, how plant diseases affect humans and animals, pathosystem genetics, and management of plant diseases.
Our extensive line of Phytopathology products facilitate the selection, isolation, growth and study of plant pathogens. With a wide range of dehydrated powder media as well as sterile solutions, we provide you with the products you need.